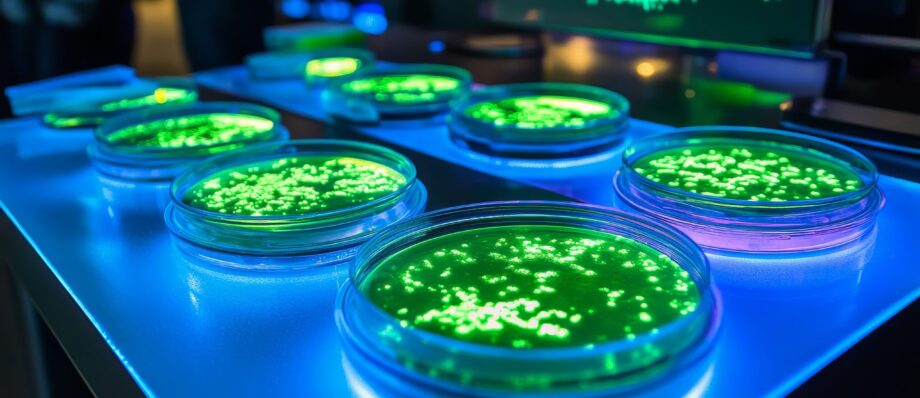

Odisha’s ₹1,113 Crore Biotech Vision Aims to Transform Bio-Economy by 2029
In a bold stride toward establishing Odisha as a bio-economy hub, the state cabinet, led by Chief Minister Mohan Charan Majhi, approved a ₹1,113.5 crore biotechnology scheme on June 6, 2025, named the Development of Biotechnology initiative. This five-year plan, set to run from 2025-26 to 2029-30, aims to harness Odisha’s rich biodiversity and research infrastructure to drive innovation in agriculture, medicine, and environmental sciences. Recent reports highlight this as a transformative step to position Odisha as a leader in India’s burgeoning biotech sector, aligning with the state’s Industrial Policy Resolution (IPR) 2022.
The biotechnology scheme, comprising 17 sub-schemes, focuses on fostering industry-academia partnerships to bridge the gap between research and practical applications. Official statements emphasize that the initiative will create a robust ecosystem for innovation, incubation, and investment, supporting the Odisha Biotechnology Policy-2024. By promoting higher education and research infrastructure, the scheme aims to develop advanced facilities for product and service development. Chief Secretary Manoj Ahuja noted that the program will empower startups and researchers, leveraging Odisha’s natural resources to address societal challenges through biotechnology advancements.
Odisha’s bio-economy vision is rooted in its unique biodiversity, with ecosystems like the Similipal National Park and coastal regions offering untapped potential for biotech research. The scheme targets key sectors, including agri-biotechnology for sustainable farming, medical biotechnology for affordable healthcare solutions, and environmental biotechnology to combat climate change. For instance, innovations in bio-fertilizers and disease-resistant crops could boost Odisha’s agricultural output, while advancements in biomedical research aim to address local health challenges like anemia and malnutrition, according to experts. The initiative also supports skill development, equipping students and researchers with expertise in cutting-edge biotech fields.
The ₹1,113 crore investment is part of Odisha’s broader strategy to align with national goals, such as India’s ambition to reach a $300 billion bio-economy by 2030. This complements the Union Cabinet’s Bio-RIDE scheme, a ₹9,197 crore initiative to advance biotechnology research and biomanufacturing nationwide. Odisha’s scheme, however, is tailored to its regional strengths, emphasizing socio-economic development through biotech innovations. Recent posts on X reflect public enthusiasm, with users calling the scheme a “visionary move” to elevate Odisha’s global standing, though some stress the need for transparent implementation to ensure funds reach grassroots innovators.
To support this vision, the state is developing biotech parks and incubation centers to nurture startups and facilitate commercialization. These hubs will connect academic institutions like the Odisha University of Agriculture and Technology with industries, fostering collaboration on projects like biofuel production and waste management solutions. The scheme also includes incentives for private investment, aligning with the Anusandhan National Research Foundation’s model, which encourages private-sector contributions to innovation. Experts suggest that such partnerships could position Odisha as a competitor to biotech hubs like Bengaluru and Hyderabad.
Despite the optimism, challenges remain. Ensuring the biotech scheme’s success requires robust monitoring to prevent mismanagement of funds, a concern echoed in discussions on X. Additionally, experts note that infrastructure development must keep pace with research to translate innovations into tangible outcomes. The state’s recent environmental initiatives, such as planting 7.5 crore saplings and banning single-use plastics in forest zones, complement the biotech focus by promoting sustainability, but coordination across sectors will be critical.
Odisha’s ₹1,113 crore biotechnology scheme marks a pivotal moment in its journey toward a knowledge-driven economy. By leveraging biodiversity, fostering innovation, and prioritizing sustainable development, the state is poised to make significant strides in the bio-economy. As the initiative unfolds, it promises to empower communities, create jobs, and position Odisha as a global biotech leader by 2029.